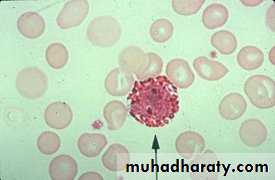

By Dr Dhafer A. Alghezi Ph.D. Cancer research / UKM.Sc. Clinical Immunology
Immune system
It is a group of structures (cells, tissues and organs) that is collectively referred to the lymphoid system.1- Primary (central): where the cells of immune system are produce &/or developed, like the thymus and bone marrow.
2- Secondary (peripheral): where the cells of immune system are functioned. like the spleen, lymph nodes, mucosa associated lymphoid tissue -MALT-, tonsils & Peyer’s Patches
Organs of immune system
The major lymphoid organs and tissues are classified into either:The cells of the immune system
neutrophil
eosinophil
basophilmast cell
macrophagemonocyte
Myeloid lineageNK cell
Th cellTc cell
B cell
Lymphoid lineageDendritic cell
Lineage?
Immune system: consists of two main categories,
these are: a Cellular part.
a Humoral (Soluble mediators) part.
A-Mononuclear phagocytes: which is the long-lived phagocytic cells, many organs contain phagocytic cells derived from blood monocytes which are manufactured in the bone marrow.
Monocyte vs phagocyte?
B- Polymorphnuclear Neutrophils: short-lived phagocytic cells, its constitute the majority of the blood leukocytes. They migrate into tissue, particularly at site of inflammation, in one-way trap. Since, it engulf material, destroy it and then die.1-phagocytes which internalize Ags and pathogenic microorganisms and degrade them and they fall into two categories:
A lymphocyte is one of the subtypes of a white blood cell (WBCs) in a vertebrate's immune system. It is an important cell because of its central role in the immune response.
There are several subpopulations of lymphocytes have been defined, including
A) B cells (for humoral, antibody-driven adaptive immunity).
B) T cells (for cell-mediated, cytotoxic adaptive immunity).
C) Natural killer (NK) cells (which function in cell-mediated, cytotoxic innate immunity).
2-Lymphocytes
B cells
a precursor of antibody-producing cells, known as plasma cells.They are genetically programmed to encode a surface receptor specific for a particular Ag.
Having recognized its specific Ag they multiply and differentiated into plasma cells, which produce large number of antibodies.
Th1: represents a group of cells which interact with MNP and helps them destroy intracellular pathogens.
Th2 : is kind of T cells that can interact with B-cells and help them to divide, differentiate and make Abs.
T-cytotoxic cell (Tc). represent group of cells that are responsible for the destruction of host cells which have become infected by viruses or other intracellular pathogen These T-cells generate their effects, either by releasing soluble proteins (cytokines) or by direct cell-cell interactions.
T-cells
They are different types of T cells with variety of functions.
Immunoregulatory T lymphocytes,
There are another group of T. cells that can suppress the immune response and this might operate through direct killing of APCs or through suppressive cytokines like TGFb or via a negative regulation of signal transduction (CTLA-4) or via idiotype network.Natural killer cells (NK)
They play a dual role in the elimination of infected and malignant cells. These cells are unique in that they have two different mechanisms of recognition:They can identify malignant or viral-infected cells by their decreased expression of histocompatibility antigens (HLA).
They can recognize antibody-coated cells and mediate ADCC.
a- large granular lymphocytes which recognize the surface changes that occur on a variety of tumor cells and virally infected cells. They recognizing cells which lack, or have lost their MHC-molecules-NK-cells- or like (macrophage, neutrophil & NK) large granulocyte lymphocytes recognize and destroy some target cells which have become coated with specific Ab in what is called Ab-dependent cell-mediated cytotoxicity (ADCC).
3-Cytotoxic cells: that recognize and destroy other cells i.e they have the capacity to kill other cells like:
3-Cytotoxic cells:
b- Eosinophil PMN: They comprise 2-5% of leukocyte and their cytoplasmic granules stain acidic dye. It is engage and damage large extracellular parasites, they damage their different targets by releasing the contents of their intracellular granules close to them. Eosinophiles also release histamine and aryle-sulphatase which inactivate histamine and some of the leukotrienes (SRS-A).a-Basophils and mast cells they have granules containing a variety of mediators that produce inflammation in surrounding tissues. they can also synthesize and secrete a number of mediators which control the development of immune reaction. Mast cells lie close to blood vessels in all tissue and basophiles are mobile, circulating cells. They accounting for less than 0.2% of leucocytes, the cytoplasmic granules that stain with basic dyes.
b- Platelets: they also release inflammatory mediators when activated during thrombogenesis or by mean of Ab-Ag complexes.
4-Auxiliary cells: other cells can mediate inflammation like
APC are a heterogeneous population of leukocytes with very efficient immunostimulatory capacity.They are the interface between the innate and adaptive immune systems.
They are found primarily in the skin, lymph node, spleen, within or underneath most mucosal epithelia and in thymus. Langerhan’s cells in the skin and interdigitating cells (IDCs) which is a migrating cell provides an efficient mechanism for carrying Ag from the skin and mucosa to the Th-cells located in the lymph node.
These APC are rich in class II MHC-molecules, which are important for presenting Ag to Th-cells.
Ag-presenting cells (APCs)
They are required by T-cells to enable them to respond to Ags.
They bind Ag via complement receptor (CD21, CD35) and Fc-gamma Receptor.
Macrophage and classical B-cells are rich in MHC-II, thus able to present Ag to T-cells and these cell also called professional APCs.
Somatic cells do not normally express MHC-II but cytokines such as IFN-gamma and TNF-alpha can induce the expression of MHC-II on some of these cells and become able to present Ag like the skin and thyroid epithelium and endothelia. These cell known as non-professional APCs.
A wide variety of molecules are involved in the development of the immune response. These includes Abs, complements and cytokines.
A-complement proteins: about 30 serum proteins, present in an inactive state, activated by different mechanisms to mediate variable functions in the immune system like; opsonization (enhanced phagocytosis), chemotaxis (unidirectional migration of the inflammatory cells), anaphylaxis (mast cells degranulation and release of further inflammatory mediator) and lysis of targeted cells.
Soluble mediators of the immune system
B- AntibodiesIt also called immunoglobulin (Igs), Abs are group of serum molecules produced by B-cells, it’s a soluble form of B-cells surface Ag-receptors. In general each Abs can bind specifically to just one Ag.
The part of an AB molecule that bind to Ag called Fab-portion and the other part called constant portion (Fc) which interact with other cells of immune system and act as opsonin which enhance phagocytosis
They are large group of molecules involved in signaling between cells. The principle sets of cytokines are :
Interferons it is important in limiting the spread of certain viral infection like IFN alpha and beta since these IFNs induce a state of antiviral resistance in uninfected tissue cells. IFN gamma which released by activated T-cells and its very important in cell-mediated immunity.
Interleukines (Ils) these are a large group of cytokines IL1-IL22 produced by T-cells, mononuclear phagocytes, most of them are involved in directing other cells to divide and differentiate.
Cytokines
Colony stimulating factors (CSFs) they are involved in directing the division and differentiation of bone marrow stem cells and the precursors of blood outside the bone marrow.Chemokines: direct movement of cells around the body, from the blood to the appropriate location. Some of the chemokines also activate cells to carry out particular functions.
Others: like TNF alpha & beta and transforming growth factors-beta.
Antigens
Immunogen is any agent capable of inducing an immune response.All immunogens are antigens, but not all Ags are immunogens.
Antigen (Ag) is any agent capable of binding specifically tocomponents of the immune response.
T-dependent antigens
Do not directly stimulate the production of antibody without the help of T cells.
Mostly proteins
require macrophages or another APC
Require T-helper cells for formation of Abs
Require major histocompatibility antigens
Memory
T-independent antigens
Can directly stimulate the B cells to produce antibody without the requirement for T cell help.Complex carbohydrates
The antigen stimulates antibody production without T-cell help (Do not require processing)
Can directly interact with B cells
Little or no memory
Epitope (antigenic determinant): it is an active region of an immunogen (or antigen) that binds to antigen-specific receptors on lymphocytes or to secreted antibodies.
Superantigen: A class of antigens that cause non-specific activation of T-cells, resulting in polyclonal T-cell activation and massive cytokine release.
Exogenous antigens
These antigens are entered to the body from the outside, for example, by inhalation, ingestion or injection.By endocytosis or phagocytosis, exogenous antigens are taken into the antigen-presenting cells (APCs) and processed into fragments. APCs then present the fragments to T helper cells (CD4+) by the use of class II MHC molecules on their surface.
Endogenous antigens
They are a part of self, and the immune system is usually tolerant to them.The loss of tolerance to self-antigens, however, can also have pathogenic implications (autoimmune diseases).
Antigenicity vs Immunogenicity
Antigenicity is the property of a substance (antigen) that allows it to react with the products of a specific immune response (antibody or T cell receptor).Immunogenicity is the property of a substance (immunogen) that endows it with the capacity to provoke a specific immune response (The ability to induce a humoral or cell mediated immune response).
Hapten
Any antigen that is unable to induce an immune response.It has the property of antigenicity but not immunogenicity.
This non antigenic substance can be immunogenic ( when?) if coupled to a larger molecule referred to as a carrier molecule
Requirements for Immunogenicity
Foreignness: (More foreign the substance, the more immunogenic it is).High molecular weight: In general, compounds of MW <1000Da (penicillin, progesterone, aspirin) are not immunogenic, while MW b/w 1000 – 6000Da (insulin, ACTH) may or may not be immunogenic and MW >6000Da (albumin, tetanus toxin) are generally immunogenic
Chemical composition: protein are the best, followed by CHO, whereas lipid and nucleic acids are weak immunogic.
Chemical complexity: the more complex the molecule have a better immunogenicity .
Degradability: Peptides composed of D-amino acids, which are resistant to enzymatic degradation, are not immunogenic, while L-isomers are susceptible to enzymes and are thus immunogenic whereas, CHO are not processed or presented and are thus unable to activate T cells, although they can activate B cells
Other factors
Genetic make-upImmune responsiveness controlled by genes mapping within the MHC
Dosage and route of administration
Threshold amount of Ag
Insufficient doses tends to render the responding cells unresponsive – tolerance
Number of doses administered
Repeated doses stimulate a stronger response
Route of Administration
Determines which organs and cell populations respond, subcutaneous (S.C.) and intramuscular better than oral or intravenous injection.
Immunologic Adjuvants
A group of agents that potentiate an immune response.It is not immunogenic by it self.
Can not evoke immune response by it self.
There are two types of adjuvants
Repository:like the Al- & Ca- salts, they act by slowing the release of immunogen when they form insoluble complex with it.
Emulsifing agent:like the Freund’s adjuvant which composed of water, oil and killed mycobacterium, the different size droplets are degraded at different rates (prolonged presence) and the induce granuloma reaction act as physical barrier, delayed it release.
Theortical activity of the adjuvants
Prolonged the presence of immunogen.
Increase size of immunogen,
providing more efficient processing of immunogen.Increase rate of Ab synthesis and release.
Local inflammatory reaction, leading to:
Increase number of cells involved in immune response.Increase the expression of MHC and co-stimulatory molecules on APCs.
The Fate of Ag after Penetration
Three major routes followed by an Ag after it has penetrated the interior of the bodyBloodstream spleen APCs activation of T and B cells circulation
Epidermal or subcutaneous inflammation Lymph nodes activation T and B cells
Gastrointestinal or respiratory MALT interaction with macrophages and lymphocytes Abs deposited in local tissue lymphocytes efferent lymphatics thoracic duct circulation